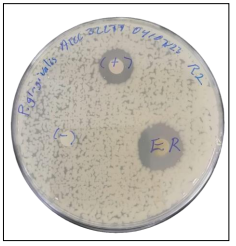
Halo de inhibici�n del aceite de romero contra P. gingivalis.
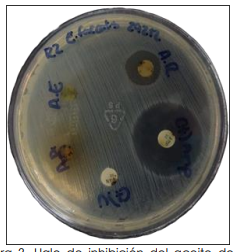
Halo de inhibici�n del aceite de romero contra E. faecalis 24 h.
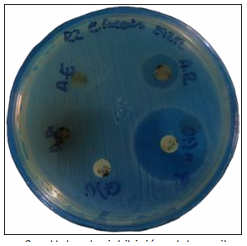
Halo de inhibici�n del aceite de romero contra E. faecalis 48 h.

CIENCIAS DE LA SALUD
Actividad antimicrobiana de Salvia rosmarinus (romero) sobre Porphyromonas gingivalis y Enterococcus faecalis
Salvia rosmarinus (rosemary) antimicrobial activity against Porphyromonas gingivalis and Enterococcus faecalis
Actividad antimicrobiana de Salvia rosmarinus (romero) sobre Porphyromonas gingivalis y Enterococcus faecalis
Investigación y Ciencia, vol. 32, núm. 92, pp. 1-9, 2024
Universidad Autónoma de Aguascalientes
Recepción: 06 Agosto 2023
Aprobación: 13 Mayo 2024
Publicación: 31 Mayo 2024
Resumen: El romero (Salvia rosmarinus) es conocida como la reina de las plantas aromáticas, una de sus mayores características además del fuerte aroma es que también es una planta utilizada con fines medicinales por la población en general, la cual ha implementado diversas maneras de consumirla. El propósito de este trabajo fue evaluar la actividad antimicrobiana que tiene el romero, para que con base en esto se pueda considerar para generar diversos productos e inclusive fármacos para su uso específico contra Porphyromonas gingivalis y Enterococcus faecalis; ya que estas bacterias se han asociado a diversas enfermedades de importancia en el país de México, como la gingivitis y periodontitis. Se determinó la actividad antimicrobiana mediante el método Kirby-Bauer, se realizó la medición de los halos de inhibición formados a partir de los discos impregnados con aceite esencial de romero, el cual mostró actividad contra P. gingivalis y E. faecalis.
Palabras clave: romero, aceite esencial, Porphyromonas gingivalis, Enterococcus faecalis.
Abstract: Rosemary (Salvia rosmarinus) is known as the queen of aromatic plants, one of its main characteristics besides its strong aroma is that it is also a plant used for medicinal purposes by the general population, which has implemented various ways of consuming it. The purpose of this work was to evaluate the antimicrobial activity of rosemary, so that based on this it can be considered to generate various products and even drugs for specific use against Porphyromonas gingivalis and Enterococcus faecalis; since these bacteria have been associated with various diseases of importance in the country of Mexico, such as gingivitis and periodontitis. The antimicrobial activity was determined using the Kirby-Bauer method, measuring the inhibition halos formed from the disks impregnated with rosemary essential oil, which showed activity against P. gingivalis and E. faecalis.
Keywords: rosemary, essential oil, Porphyromonas gingivalis, Enterococcus faecalis.
INTRODUCCIÓN
El romero, una planta que ha sido utilizada durante muchos años con fines medicinales, que benefician la salud y bienestar de la persona que lo consume (Secretaría de Salud, 25 de marzo de 2023). El objetivo a cumplir en esta investigación es conocer la actividad antimicrobiana del romero (Salvia rosmarinus) contra Porphyromonas gingivalis y Enterococcus faecalis.
El romero también es conocido como Salvia rosmarinus y anteriormente era llamada Rosmarinus officinalis; es una planta perteneciente a la familia Lamiaceae, esta familia es nativa del mediterráneo. Este arbusto de hojas perennes es muy aromático, por lo que se le considera como la reina de las plantas aromáticas (AGEXPORT [Asociación de Exportadores de Guatemala], 2021). Su principal producción en la república mexicana es en el estado de México y en el estado de Baja California (Secretaría de Agricultura y Desarrollo Rural, 16 de abril de 2017). El romero es usado como planta medicinal en los estados de Guerrero, Hidalgo, Jalisco, Michoacán, Ciudad de México, Morelos, Oaxaca, Puebla, Sonora, Tlaxcala y Veracruz (Ávila-Sosa et al., 2011), agregando a Tepic, Nayarit; estado en el cual su uso más típico es el té de romero para fines medicinales gastrointestinales.
Se tenía el conocimiento de que el término era derivado del griego (rhops y myrinos) que significa arbusto marino, después se conoció que el nombre genérico era Rosmarinus, derivado del latín, donde se conocía como ros (rocío) y marinus (mar) como rocío del mar. En la actualidad los etimologistas consideran que éste es la unión de dos vocablos griegos; rhos (arbusto) y myrinos (aromático), la cual expresa la principal característica de la planta y el nombre officinalis refiere que es una planta usada con fines medicinales (AGEXPORT [Asociación de Exportadores de Guatemala], 2021).
La gingivitis es una de las enfermedades bucodentales más comunes, se caracteriza por el sangrado e inflamación del tejido gingival, dolor y en algunas ocasiones puede producir halitosis; si no es tratada a tiempo esta enfermedad se puede tornar grave, el avance de este proceso provoca que las encías se separen de los dientes, facilitando la proliferación bacteriana por debajo de ellas (placa bacteriana subgingival). La infección se hará más profunda hasta llegar a afectar a las estructuras del soporte del diente, incluyendo el hueso alveolar (Bonet & Garrote, 2014), con la perdida subsecuente de la inserción al cemento y, finalmente, la pérdida del diente (Kawar et al., 2011).
Otras complicaciones asociadas a la enfermedad periodontal es la bacteriemia; se ha descrito que la periodontitis puede afectar a la incidencia y el espectro bacteriano de la bacteriemia; además la enfermedad periodontal puede ser un factor de riesgo significativo en el desarrollo de enfermedades sistémicas y síndromes geriátricos (Instituto Mexicano del Seguro Social, 2012; Maestre Vera, Mateo Maestre, & Sánchez Santana, 2008).
En México, según los Resultados del Sistema de Vigilancia Epidemiológica de Patología Bucales SIVEPAB 2020, realizado a diferentes grupos de edad de 20 a 34, de 35 a 49, de 50 a 64, de 65 a 79 y de 80 y más años se observó una prevalencia de gingivitis de casi 50% en todos los grupos de edad; lo que demuestra que la gingivitis puede afectar a cualquier grupo de edad y es por esto que se debe considerar la importancia bucodental (Secretaría de Salud, 2022).
El objetivo del tratamiento de la enfermedad periodontal es reducir la inflamación y mejorar el estado de la encía en su etapa previa: gingivitis. La gingivitis es reversible siempre y cuando se elimine la placa bacteriana que se encuentre alrededor de los dientes (Barbed, 2010).
En la Guía de Práctica Clínica GPC. Diagnóstico y Manejo de los Problemas Bucales en el Adulto Mayor en cuanto a la gingivitis y diversos trastornos bucodentales (Instituto Mexicano del Seguro Social, 2012) se establece que en el tratamiento a los pacientes con enfermedad periodontal debe incluirse además del tratamiento del estomatólogo una terapia complementaria que incluye control de factores de riesgo, utilización de antibióticos locales o sistémicos, cepillado dental, uso de hilo dental, pulido y profilaxis, dependiendo del estado de la enfermedad periodontal y enjuagues bucales con clorhexidina 0.12%; es decir, los productos indicados para mejorar la gingivitis tienen que estar formulados con activos que combatan los tres problemas principales que se asocian a la periodontitis inicial: placa, sangrado e inflamación (Barbed, 2010).
En este trabajo se estudió la actividad antimicrobiana del romero, un método natural con fines medicinales que, entre las enfermedades para las que se emplea, destacan enfermedades inflamatorias y el tratamiento de lesiones orales (Flores-Villa, Sáenz-Galindo, Castañeda-Facio, & Narro-Céspedes, 2020).
Composición química
El aceite esencial de romero tiene una composición que varía según la procedencia de la planta, por ejemplo: una planta de romero proveniente de Guatemala puede contener metabolitos o la cantidad de éstos puede ser diferente con una planta de romero proveniente de México, también se debe considerar la parte de la planta obtenida y la manera en la que éste se recolecta (AGEXPORT [Asociación de Exportadores de Guatemala], 2021).
Se pueden diferenciar 3 quimiotipos diferentes: cineoliferum (este contiene un alto porcentaje de 1,8-cineol), camforiferum (con más de 20% de alcanfor) y verbenoniferum (con más de 15% de verbenona) (AGEXPORT [Asociación de Exportadores de Guatemala], 2021; Loarte Mauricio & Hurtado Huanca, 19 de diciembre de 2019). El aceite esencial de romero contiene diversos componentes principales: alcanfor, 1,8-cineol, apineno y otros monoterpenos como borneol, β-pineno, limoneno y p-cimeno; también existen lactonas sesquiterpénicas (carnosol, rosmanol, epirosmanol, isorosmanol, 7-metoxirosmanol, rosmadial); ácidos triterpénicos (ácido ursólico, ácido betulínico); alcoholes triterpénicos (α y β-amirina, betulina); ácidos fenólicos (cafeico, clorogénico, rosmarínico); flavonoides (luteolina, apigenina, genkwanina, diosmetina, hispidulina, 5-hidroxi-7, 4-dimetoxiflavona, cirsimaritina) y los correspondientes heterósidos (AGEXPORT [Asociación de Exportadores de Guatemala], 2021; Avila-Sosa et al., 2011); diterpenos como la picrosalvina, el carnosol, el isorosmanol, rosmadial, rosmaridifenol y romariquinona, triterpenos como el ácido oleanólico y ursólico, y sus 3-acetil-ésteres. De igual forma, dentro de su composición hay flavonoides tales como la cirsimarina, diosmina, hesperidina, homoplantiginina, fegolopolina, nepetina y nepitrina, y polifenoles como el ácido rosmarínico, ácido clorogénico, ácido cafeico y ácidos fenólicos derivados del ácido cinámico. Los compuestos activos de la salvia y el romero son los ácidos fenólicos, flavonoides, pigmentos naturales (capsaicina y curcumina) y terpenos (rosmanol, ácido carnósico, carnosol, epirosmanol e isorosmanol) (Avila-Sosa et al., 2011).
Porphyromonas gingivalis. Es una bacteria gram negativa que crece de manera anaerobia y puede producir varios factores de virulencia, como su capacidad de infectar células periodontales obteniendo una protección contra las defensas del huésped. Está bacteria se ha convertido en un factor de riesgo para las infecciones pulmonares, parto pretérmino y bajo peso al nacer. Su presencia en placas ateroscleróticas puede incrementar el riesgo de infarto al miocardio (Orrego-Cardozo, Parra-Gil, Salgado-Morales, Muñoz-Guarín, & Fandiño-Henao, 2015).
-Morfología: Esta bacteria es un bacilo corto o cocobacilo, con medidas de 0.5 - 0.8 um x 1 - 3.5 um, anaerobio, gram negativa, que habita el área subgingival. La pared celular contiene endotoxinas a nivel de la membrana externa, no tiene flagelos, no son esporulados, son capsulados y tienen abundantes fimbrias de diversos tipos, de manera superficial muestra vesículas que contienen una gran variedad de enzimas. Es posible que produzca gran cantidad de múltiples enzimas con capacidad importante para degradar los compuestos proteicos (Ramos Perfecto, Moromi Nakata, & Martínez Cadillo, 2011).
Enterococcus faecalis. Los Enterococci se consideran entre los principales agentes causales de infecciones nosocomiales, sobre todo destacan Enterococcus faecalis y Enterococcus faecium. Actualmente se clasifican como la segunda o tercera causa de infecciones nosocomiales en EE. UU., son responsables de infecciones graves como septicemia, infecciones del sistema nervioso central (SNC), infecciones de piel y tejidos blandos, endocarditis, neumonía y sepsis intraabdominal (Arredondo García, Echeguren Flores, Arzate Barbosa, & Medina Cortina, 2018) y en la cavidad oral se han encontrado en periodontitis apical (Ardila Medina, Maggiolo Villalobos, Dreyer Arroyo, Armijo Pérez, & Silva Steffen, 2014).
-Morfología: Enterococcus faecalis en agar sangre pueden identificarse por las colonias pequeñas, lisas y de borde uniforme, de coloración blanquecina o crema y en el agar telurito es posible observarse en colonias con coloración negra (Ryan, Ahmad, Drew, Reller, & Weissman, 2021). Dentro de la patogenia los Enterococcus faecalis se encuentran en cavidad oral; a pesar de que esta bacteria tiene como hábitat regular el intestino también se ha identificado en la mucosa oral, lengua, bolsas periodontales y conductos radiculares (Ardila Medina et al., 2014).
MATERIALES Y MÉTODOS
Bacterias
Se utilizaron P. gingivalis ATCC 32777 y E. faecalis ATCC 24212.
Prueba de sensibilidad
El material vegetal de romero se obtuvo en el mercado de la ciudad de Chilpancingo, Guerrero Baltazar R Leyva Mancilla; se eligieron las partes aéreas en condiciones óptimas, se usó material fresco, mediante Soxhlet se realizó la extracción de los metabolitos del romero. Se utilizaron 400 ml de etanol para 60 g de romero, que realizó tres ciclos para la obtención de extracto etanólico de romero; una vez obtenido el extracto etanólico se realizó el proceso de destilación para obtener el aceite esencial.
La prueba de sensibilidad microbiana se realizó por el método Kirby-Bauer en agar Mueller-Hinton; se sembraron P. gingivalis y E. faecalis; se utilizaron discos de papel filtro impregnados con aceite esencial de romero, agua destilada (control -), digluconato de clorhexidina al 0.12% (control +) para P. gingivalis, ampicilina en concentración de 10 mg (control +) para E. faecalis se incubó durante 24 h en condiciones de anaerobiosis, cada prueba se realizó por triplicado. Tras depositar los discos en la placa éstas se incubaron en posición invertida durante el tiempo y la temperatura adecuada para el crecimiento del microorganismo. Una vez transcurrido el tiempo de incubación se midió el halo de inhibición con un vernier. La presencia y el tamaño del halo proporciona información sobre la capacidad antimicrobiana del compuesto estudiado (Cantón, 2010; Pérez Esteve & Rivas Soler, 2021).
RESULTADOS
P. gingivalis ATCC 32777 presentó sensibilidad ante el aceite esencial de romero teniendo un halo promedio de 26 mm, mayor que el digluconato de clorhexidina que obtuvó un halo promedio de 23 mm (tabla 1, figura 1).

E. faecalis ATCC 29212; después de 24 y 48 h de incubación el aceite de romero generó sensibilidad con un halo de 13.5 mm, la ampicilina con un halo de 27 mm (tabla 1, figura 2, figura 3).

DISCUSIÓN
En el presente estudio se obtuvieron resultados que mostraron una actividad antimicrobiana in vitro con una concentración de 60 mg/ml teniendo un halo inhibición de 26 mm contra P. gingivalis ATCC 32777 y 13.5 mm contra E. faecalis ATCC de 24212, por el metodo de Kirby-Bauer. Nuestros resultados coinciden con lo reportado por Purca Peña (2013); él utilizó un extracto etanólico de romero contra microorganismos presentes en saliva, obtuvó halos de inhibición con diámetros hasta de 20.56 mm; los halos de inhibición obtenidos fueron mayores que los obtenidos por los grupos controles (clorhexidina a 0.12%); en el presente trabajo encontramos una actividad del aceite de romero mayor al control positivo (clorhexidina 0.12%) con un halo de 26 mm contra P. gingivalis.
Diversos metabolitos se han señalado por tener actividad antimicrobiana contra diferentes bacterias; Purca Peña (2013) señala que la actividad antimicrobiana de Rosmarinus officinalis puede deberse a la acción de flavonoides, terpenoides, polifenoles, taninos y aceites esenciales que actúan sobre la membrana citoplasmática de las bacterias que conduce a una pérdida de iones de potasio, lo que genera autolisis de la célula bacteriana; de igual manera aumenta la permeabilidad de la membrana y desvanece su potencial, generando en la bacteria pérdida de motilidad; el transporte de la membrana y la síntesis de ATP la hace vulnerable al ataque inmunológico y potencia los antibióticos; lo que puede explicar los resultados obtenidos en esta investigación.
Respecto a E. faecalis se obtuvo un halo de inhibición de 13.5 mm menor al obtenido por el control positivo (27 mm), así como al obtenido por el aceite contra P. gingivalis; sin embargo, no puede descartarse la actividad antimicrobiana sobre esta bacteria; más estudios se consideran necesarios donde se consideren diferentes concentraciones del aceite. Los autores del presente trabajo consideramos que estos resultados pueden tomarse para señalar la importancia de la aplicación de fitofármacos en la terapia odontólogica periodontal, donde el romero podría ser un excelente aliado contra las patologías periodontales.
CONCLUSIONES
El aceite esencial de romero tiene actividad antimicrobiana en la concentración evaluada contra los microorganismos probados, teniendo mayor actividad contra P. gingivalis, lo que alienta su potencial en un futuro cercano como una alternativa terapéutica en la enfermedad periodontal.
REFERENCIAS
AGEXPORT (Asociación de Exportadores de Guatemala). (2021). Romero, Salvia rosmarinus. Proyecto Mipymes y Cooperativas + Competitivas. Autor. https://www.export.com.gt/documentos/guia-de-cultivos/guia-de-cultivo-de-romero.pdf
Ardila Medina, C. M., Maggiolo Villalobos, S., Dreyer Arroyo, E., Armijo Pérez, J., & Silva Steffen, N. (2014). Enterococcus faecalis en dientes con periodontitis apical asintomática. Revista Archivo Médico de Camagüey, 18(4), 415-423. http://scielo.sld.cu/scielo.php?script=sci_arttext&pid=S1025-02552014000400007&lng=es&tlng=es
Arredondo García, J. L., Echeguren Flores, A. M., Arzate Barbosa, P., & Medina Cortina, J. H. (2018). Susceptibilidad antimicrobiana de Enterococcus faecalis y faecium en un hospital de tercer nivel. Revista Latinoamericana de Infectología Pediátrica, 31(2), 56-61. https://www.medigraphic.com/cgi-bin/new/resumen.cgi?IDARTICULO=82714
Avila-Sosa, R., Navarro-Cruz, A. R., Vera-López, O., Dávila-Márquez, R. M., Melgoza-Palma, N., & Meza-Pluma, R. (2011). Romero (Rosmarinus officinalis L.): Una revisión de sus usos no culinarios. Ciencia y Mar, 43, 26–36. https://biblat.unam.mx/hevila/Cienciaymar/2011/no43/3.pdf
Barbed, L. A. (2010). Gingivitis. Farmacia profesional, 24(2), 66-68. https://www.elsevier.es/es-revista-farmacia-profesional-3-articulo-gingivitis-X0213932410485638
Bonet, R., & Garrote, M. (2014). Enfermedades periodontales. Farmacia profesional, 28(1), 23-27.
Cantón, R. (2010). Lectura interpretada del antibiograma: una necesidad clínica. Enfermedades Infecciosas y Microbiología Clínica, 28(6), 375–385. https://doi.org/10.1016/j.eimc.2010.01.001
Flores-Villa, E., Sáenz-Galindo, A., Castañeda-Facio, A. O., & Narro-Céspedes, R. I. (2020). Romero (Rosmarinus officinalis L.): Su origen, importancia y generalidades de sus metabolitos secundarios. Tip revista especializada en ciencias químico-biológicas, 26. doi: https://doi.org/10.22201/fesz.23958723e.2020.0.266
Gobierno de México. (2022). Resultados del Sistema de Vigilancia Epidemiológica de Patologías Bucales SIVEPAB 2020 [Documento en pdf]. Autor. https://www.gob.mx/cms/uploads/attachment/file/765740/resultadosSIVEPAB_2020.pdf
Instituto Mexicano del Seguro Social. (2012). Guía de Práctica Clínica GPC. Diagnóstico y Manejo de los Problemas Bucales en el Adulto Mayor [Documento en pdf descargable]. Autor. http://www.imss.gob.mx/sites/all/statics/guiasclinicas/583GER.pdf
Kawar, N., Gajendrareddy, P. K., Hart, T. C., Nouneh, R., Maniar, N., & Alrayyes, S. (2011). Periodontal disease for the primary care physician. Disease-a-Month, 57(4), 174–183. doi: https://doi.org/10.1016/j.disamonth.2011.03.003
Loarte Mauricio, A. M., & Hurtado Huanca, A. (19 de diciembre de 2019). Efecto Antibacteriano del Rosmarinus Officinalis en la disminución del Streptococcus Mutans, Adolescentes entre los 12 Y 15 Años de edad, Cerro de Pasco del 2018. Universidad Nacional Daniel Alcides Carrion. http://repositorio.undac.edu.pe/handle/undac/1803
Maestre Vera, J. R., Mateo Maestre, M., & Sánchez Santana, P. (2008). Bacteriemia secundaria a procedimientos odontológicos periodontales. Revista Española de Quimioterapia, 21(3), 153-156. https://seq.es/revista-de-la-seq/2008/septiembre-2008-vol-213-143-202/
Orrego-Cardozo, M., Parra-Gil, M. A., Salgado-Morales, Y. P., Muñoz-Guarín, E., & Fandiño-Henao, V. (2015). Porphyromonas gingivalis y enfermedades sistémicas. CES Odontología, 28(1), 57-73. http://www.scielo.org.co/scielo.php?script=sci_arttext&pid=S0120-971X2015000100006&lng=en&tlng=es
Pérez Esteve, E., & Rivas Soler, A. (2021). Determinación de la sensibilidad de los microorganismos frente a antimicrobianos de origen natural y la concentración mínima inhibitoria por métodos fenotípicos. Universitat Politècnica de València. http://hdl.handle.net/10251/167611
Purca Peña, T. P. (2013). Efectividad antibacteriana "in vitro" del extracto etanólico de Rosmarinus officinalis (romero) sobre flora salival (Tesis de Cirujano Dentista). Universidad Nacional Mayor de San Marcos. https://docs.bvsalud.org/biblioref/2018/03/880127/efectividad-antibacteriana-in-vitro-del-extracto-etanolico-de-r_mnpx4pV.pdf
Ramos Perfecto, D., Moromi Nakata, H., & Martínez Cadillo, E. (2011). Porphyromonas gingivalis: patógeno predominante en la periodontitis crónica. Odontología Sanmarquina, 14(1), 34–38. https://sisbib.unmsm.edu.pe/bvrevistas/odontologia/2011_n1/pdf/a11.pdf
Ryan, K. J., Ahmad, N., Drew, W. L., Reller, L. B., & Weissman, S. (2021). Estreptococos y enterococos. En K. J. Ryan (Ed.), Sherris & Ryan. Microbiología Médica (8ª. ed., capítulo 25). McGraw-Hill. https://accessmedicina.mhmedical.com/content.aspx?bookid=3217§ionid=268780852
Secretaría de Agricultura y Desarrollo Rural. (16 de abril de 2017). Del Mediterráneo llegó el romero a nuestras mesas [Blog]. https://www.gob.mx/agricultura/articulos/del-mediterraneo-llego-el-romero-a-nuestras-mesas#:~:text=Los%20estados%20mexicanos%20productores%20de,por%20ciento%20del%20total%20nacional
Secretaría de Salud. (25 de marzo de 2023). 082. Caries, gingivitis y maloclusión, afecciones bucales más comunes entre la población mexicana [Nota de prensa]. https://www.gob.mx/salud/prensa/082-caries-gingivitis-y-maloclusion-afecciones-bucales-mas-comunes-entre-la-poblacion-mexicana
Notas de autor
rreyes@uagro.mx
Información adicional
redalyc-journal-id: 674